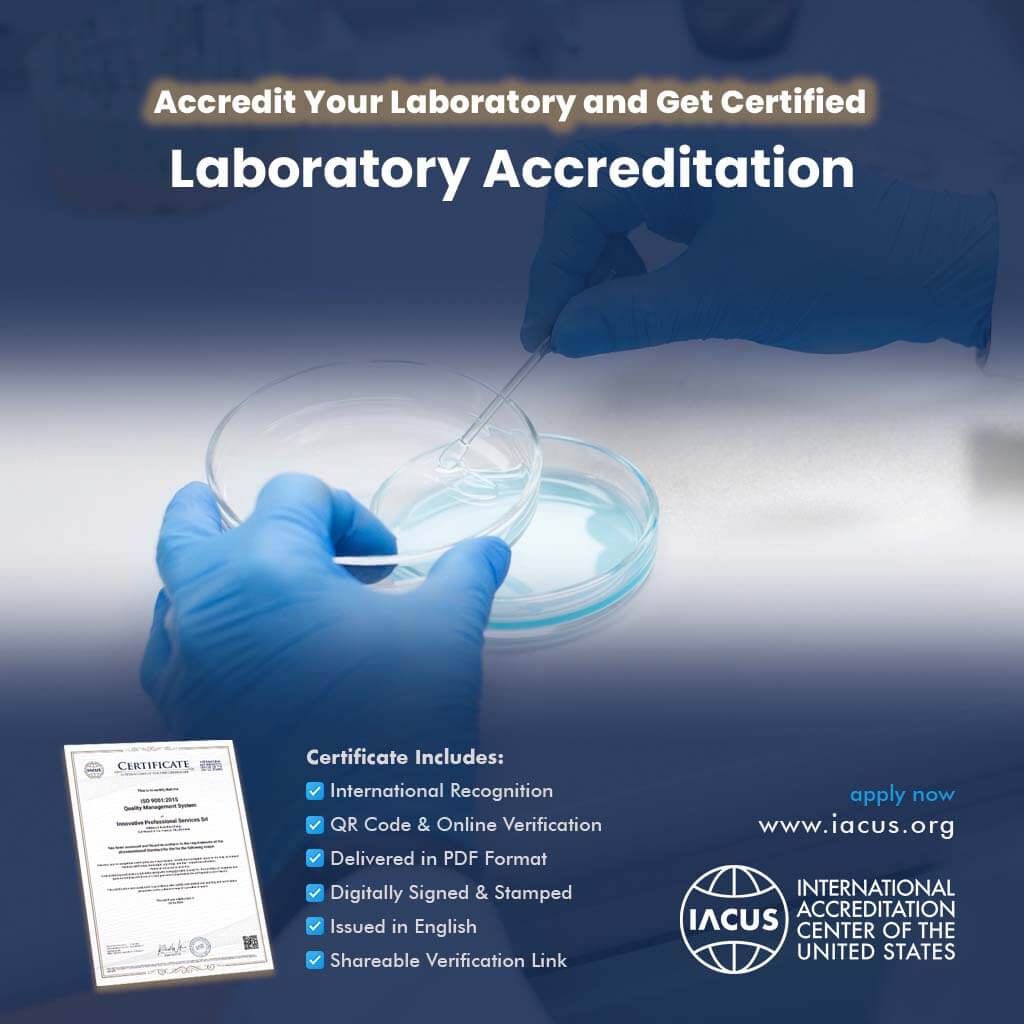

- KEY DETAILS✓ 1 Verified certificate valid for 1 year
✓ Full refund if application is denied
✓ Verifiable via QR code and link
✓ International accreditation
✓ Apply online – no physical inspection
✓ Delivered in 7 business days - CERTIFICATE INCLUDES✓ International recognition
✓ QR code & online verification
✓ Delivered in PDF format
✓ Digitally signed & stamped
✓ Issued in English
✓ Shareable verification link - HOW CAN I APPLY?✓ Add to cart.
✓ Enter your company details.
✓ Select your company’s fields of activity.
✓ Proceed to the payment step.
✓ Complete your payment.
✓ Receive your certificate by email. - INTENDED AUDIENCE✓ Companies and institutions
✓ Factories and producers
✓ Manufacturers and service providers
✓ Exporters and international traders
✓ NGOs and non-profit organizations
✓ Consulting, training centers, and academies
Description
Laboratory Accreditation and Certificate – Ensure Accuracy and Reliability with Global Standards
What Does Laboratory Accreditation and Certificate Stand For?
Laboratory Accreditation and Certificate represent official recognition granted to laboratories that meet international standards of testing, calibration, and quality assurance. It proves that a laboratory operates in compliance with global requirements, ensuring reliable and traceable results.
What Is Laboratory Accreditation and Certificate?
This accreditation ensures that a laboratory follows international protocols such as ISO/IEC 17025 and other recognized standards. Accredited laboratories demonstrate technical competence, accuracy in testing, and commitment to quality management, building trust among clients, regulators, and industry partners.
When Is Laboratory Accreditation Awarded?
Laboratory Accreditation is awarded after a thorough assessment of technical procedures, staff qualifications, equipment, management systems, and quality assurance practices. Once compliance is demonstrated, the laboratory receives certification valid for a defined period, renewable upon review.
Who Should Apply for Laboratory Accreditation and Certificate?
Laboratory Accreditation is highly recommended for:
✓ Testing and calibration laboratories
✓ Research and development labs
✓ Medical and clinical laboratories
✓ Industrial and environmental testing centers
✓ University and academic research labs
Any laboratory that provides testing or calibration services can benefit from accreditation.
Why Is Laboratory Accreditation Important?
For laboratories, accreditation provides:
✓ International recognition and compliance with global standards
✓ Verified accuracy and reliability of test results
✓ Increased client and regulatory trust
✓ Competitive advantage in scientific and industrial sectors
✓ Proof of technical competence and quality assurance
Why Should You Get Laboratory Accreditation and Certificate?
Laboratories should obtain accreditation to prove their technical competence, enhance credibility, and expand opportunities for partnerships. Accreditation improves quality, ensures compliance with industry regulations, and positions the laboratory as a trusted global provider of reliable testing services.
Which Institutions Use Laboratory Accreditation?
✓ Independent Testing Laboratories
✓ Calibration and Measurement Labs
✓ Medical and Clinical Labs
✓ Academic and Research Institutions
✓ Industrial and Environmental Labs
Laboratory Accreditation is valuable for all institutions providing testing, analysis, and calibration services.
What Are the Advantages of Laboratory Accreditation and Certificate?
Key benefits of Laboratory Accreditation include:
✓ Verified compliance with international standards (ISO/IEC 17025)
✓ Enhanced reputation and global credibility
✓ Reliable and traceable test results
✓ Increased customer and regulatory confidence
✓ Stronger competitiveness in local and international markets
Certificate Features
✓ International Recognition
✓ QR Code & Online Verification
✓ Delivered in PDF Format
✓ Digitally Signed & Stamped
✓ Issued in English
✓ Shareable Verification Link
Application Process
✓ Add to cart. You can add multiple certifications before proceeding to checkout.
✓ Enter your company details.
✓ Select your company’s fields of activity.
✓ Proceed to the payment step.
✓ Complete your payment.
✓ Receive your certificate by email.
✓ Certification will be reviewed, approved, and delivered via email within 7 business days.
✓ If your application is not approved, a full refund will be issued. It comes with a 100% Money-Back Guarantee.
Key Considerations
✓ Certification is accredited and globally recognized.
✓ Each certificate includes a QR code and online verification link.
✓ The process is fully online, transparent, and efficient.
✓ Full refund guarantee if the certification is not approved.
Validity & Renewal
Your certificate will be valid for 1 year, in line with global accreditation practices.
Annual renewal is available via our website.
Affordable Fee
We use digital evaluations rather than expensive on-site audits, delivering the same internationally accredited certification at a lower cost, without compromising on quality or global recognition.
100% Money-Back Guarantee
If your certification is not approved, we provide a full refund. The process is risk-free, transparent, and internationally valid.
Frequently Asked Questions (FAQ)
How long does the process take?
Certificates are issued within 7 business days of application.
How can certificates be verified?
Each certificate includes a QR code and verification link, accessible online worldwide.
Content
SERVICE
- This service provides accreditation certification for companies and institutions.
- If the accreditation application is denied, there is a 100% money-back guarantee. The fee you paid will be refunded in full.
1 CERTIFICATE
- International accreditation certificate
- QR code & online verification
- Delivered in PDF format
- Digitally signed & stamped
- Issued in English
- Shareable verification link
- Valid for one year but renewable
Application & Delivery
Application & Delivery
- Click the "Add to Cart" button
Add the certification to your cart. You can add multiple certifications before proceeding to checkout.
- Enter your company details
Fill in your company name, full company address, and select company fields of activity on the cart page. If necessary, we may request additional information and documents via email.
- Pay and receive your certificate in 7 business days
Complete the secure payment. Once your application is verified, you will receive your digital accreditation certificate within 7 business days.
- Full refund if application is denied
If the application is denied, there is a 100% money-back guarantee. The fee you paid will be refunded in full.
Sample Certificate